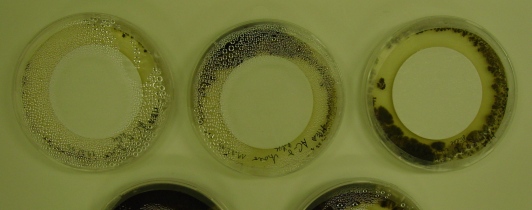

Efficacy of biocidal equipped coatings against algae or fungi
Environment, Hygiene and Sensor Technology
| Measurement | Testing the efficacy of biocidal equipped coatings against algae or fungi |
| Standards | DIN EN 15458:2007-10 (D), DIN EN 15457:2007-10 (D) |
| Measurement object | Special designed specimen (diameter 5 cm) with coating (e.g., plaster, paints, varnish), not biocidal equipped reference probe necessary |
| Area of test specimen | Approx. 20 cm² |
| Thickness of test specimen | Varies according to type of coating from 0.5 to approx. 20 mm |
| Processing | According to given requirements |
| Number of specimen | For each tested variant 15 specimen |
| Test duration | 4 to 8 weeks |
| Test strains | According to relevant standards, on request also further test strains from own collection |
| Conditioning | On request also special conditioning possible: accelerated carbonation, watering, etc. |